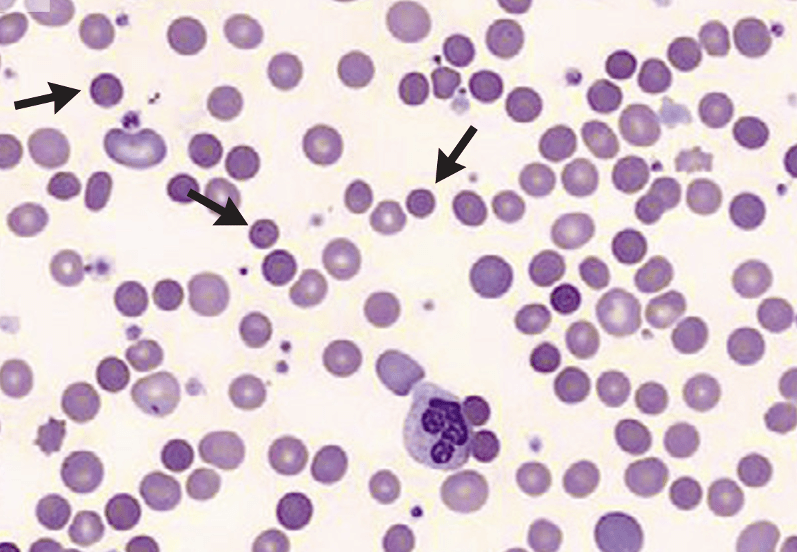

Miss Lam is a 28-year-old female who attends the clinic because she is tired all the time and is short of breath with minor exertion. She indicates that the symptoms have been ongoing for about 2 weeks and lately she has noticed slight yellowish discolouration of her eyes.
History
Lam used to be able to do her Zumba class before but for the past week she has had to stop halfway because of shortness of breath. She is also concerned as her friends at the gym have remarked that she looks pale and her eyes had taken on a tinge of yellow. She has also recently noted pain involving the small joints of her hand and feet which comes off and on, sometimes with morning stiffness.
She has been well previously with no previous hospitalisation and is not on any medication. She has removed red meat from her diet but takes fish and white meat. No food restrictions were reported otherwise.
She has no complaints of chest pain, recent infections, cough or fever. There is no loss of weight or appetite and no significant abdominal symptoms such as vomiting, abdominal pain or change in bowel habits . There is no bleeding tendency and her menses is regular.
Lam works as a lawyer in a legal firm in Kuala Lumpur and lives alone. She is partnered, a non-smoker with occasional alcohol intake during weekends, on oral contraceptives and is financially independent
Physical examination
Miss Lam appeared alert, slim, in good nutritional status and not in acute distress. There was moderate pallor with faint scleral icterus . A faint red rash was seen over the bridge of her nose. No retinal bleeds were observed. No oral ulcers or bleeding was noted

Vital signs showed the following: weight: 52kg, height: 170cm, T: 37.0oC, BP: 110/70 mmHg, PR: 72/min, RR: 14/min.
Cardiovascular examination showed normal heart sounds with no murmurs. Breath sounds were normal on lung examination with no crepitations or ronchi.
On abdominal examination, there was a palpable tip of spleen with no palpable liver or abdominal mass. Gynaecological examinations revealed no abnormalities. No peripheral lymphadenopathy was noted.
No neurological abnormalities were elicited. Mild swelling and tenderness of small finger joints was present but but there was full range of movement and no joint deformities were noted.
Tasks (Part I) – hypothesis generation
- List three possible diagnosis in order of likelihood (principal diagnosis and differential/other diagnosis).
- For each possible diagnosis listed, provide findings from the history and clinical examinations or patient risk factors that would support your diagnosis.
- For each possible diagnosis listed, provide findings opposing the hypothesis, or findings that were expected but not present or elicited during the clinical examination.
- Based on your reasoning above, decide on the first-line laboratory and imaging tests that you would want to perform in the patient. For each test, state how the results may help you to affirm or disprove your hypothesis.
Investigations (first-line)
Haematology & Clinical Chemistry
| Reference range | Units | ||
| Full blood count | |||
| WBC | 8.6 | 4.0 – 11.0 | 109/L |
| RBC | 2.8 | 3.8 – 4.8 | 1012/L |
| Hb | 84 | 120 – 160 | g/L |
| Hct | 0.27 | 0.37 – 0.47 | |
| MCV | 100 | 77 – 97 | fL |
| MCH | 30 | 27 – 32 | pg |
| MCHC | 302 | 315 – 345 | g/L |
| RDW | 17.6 | 11.5 – 15.0 | % |
| Platelet | 152 | 150 – 400 | 109/L |
| Reticulocyte | |||
| Reticulocyte (absolute) | 352 | 50 – 150 | 109/L |
| Reticulocyte | 12.6 | 0.5 – 1.5 | % |
| Total white differential counts | |||
| Neutrophils | 2.3 | 2.0 – 7.5 | 109/L |
| Lymphocytes | 5.2 | 1.5 – 4.0 | 109/L |
| Monocytes | 0.7 | 0.2 – 0.8 | 109/L |
| Eosinophils | 0.4 | 0.04 – 0.4 | 109/L |
| Basophils | 0.01 | 0.02 – 0.1 | 109/L |
| Serum electrolytes | |||
| Sodium | 138 | 135 – 148 | mmol/L |
| Potassium | 4.0 | 3.5 – 5.5 | mmol/L |
| Chloride | 99 | 95 – 105 | mmol/L |
| Calcium | 2.5 | 2.1 – 2.7 | mmol/L |
| Magnesium | 0.9 | 0.7 – 1.0 | mmol/L |
| Urea | 4.2 | 2.5 – 6.5 | mmol/L |
| Creatinine | 87 | 45 – 120 | mmol/L |
| Haematinic assays | |||
| Serum vitamin B12 | 484 | 157 – 672 | pmol/L |
| Serum folate | 4 | 2 – 20 | pmol/L |
| Serum Iron | 8.7 | 9.0 – 30.4 | pmol/L |
| Serum transferrin | 1.2 | 2.0 – 3.3 | pmol/L |
| Transferrin saturation | 25 | 20 – 45 | % |
| Ferritin | 415 | 10 – 291 | ug/L |
| Inflammatory biomarkers | |||
| C-reactive protein (CRP) | 16.8 | < 10 | mg/L |
| Erythrocyte sedimentation rate (ESR) | 50.7 | < 20 | mm/hour |
Tasks (Part II) – information integration and interpretation
- Refine your diagnosis based on the results of the investigation and reprioritise if necessary
- Formulate the next steps in investigation for confirmation of diagnosis, patient assessment prior to treatment initiation and prognostication
Investigations (additional)
Haematology & Clinical Chemistry
| Liver function test | |||
| Albumin | 39 | 32 – 48 | g/L |
| Total bilirubin | 54 | < 17 | umol/L |
| Unconjugated bilirubin | 37 | < 12 | umol/L |
| Alkaline phosphatase | 62 | 45 – 129 | U/L |
| Alanine aminotransferase | 22 | 10 – 49 | U/L |
| Aspartate transaminase | 18 | < 34 | U/L |
| Gamma-glutamyl transferase | 11 | < 73 | U/L |
| Lactate dehydrogenase | 487 | 140 – 280 | U/L |
| Haptoglobin | < 0.1 | 0.5 – 2.2 | g/L |
Immunology
| anti-dsDNA | Positive |

Anti-nuclear antibody
Positive (homogenous pattern)
Titre: 160
Immunohaematology
| DAT (polyspecific) | Positive (3+) |
| Anti-IgG | 3+ |
| Anti-C3d | 2+ |
Tasks (Part III) – mechanistic diagram and management
- Develop a mechanistic diagram outlining the scientific mechanisms behind the major signs, symptoms and laboratory results seen in the patient
- Develop a basic care plan for the patient which should address the physical, mental, and social wellbeing needs of the patient